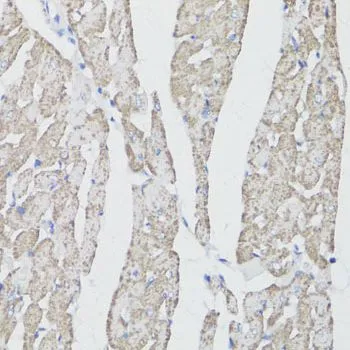

WB analysis of various sample lysates using GTX53909 CD59 antibody. The signal was developed with ECL plus-Enhanced. Dilution : 1:500 Loading : 25microg per lane
CD59 antibody
GTX53909
ApplicationsWestern Blot, ImmunoHistoChemistry, ImmunoHistoChemistry Paraffin
Product group Antibodies
TargetCD59
Overview
- SupplierGeneTex
- Product NameCD59 antibody
- Delivery Days Customer7
- Application Supplier NoteWB: 1:500 - 1:2000. IHC-P: 1:50 - 1:200. *Optimal dilutions/concentrations should be determined by the researcher.Not tested in other applications.
- ApplicationsWestern Blot, ImmunoHistoChemistry, ImmunoHistoChemistry Paraffin
- CertificationResearch Use Only
- ClonalityPolyclonal
- ConjugateUnconjugated
- Gene ID966
- Target nameCD59
- Target descriptionCD59 molecule (CD59 blood group)
- Target synonyms16.3A5, 1F5, EJ16, EJ30, EL32, G344, HRF-20, HRF20, MAC-IP, MACIF, MEM43, MIC11, MIN1, MIN2, MIN3, MIRL, MSK21, p18-20, CD59 glycoprotein, 1F5 antigen, 20 kDa homologous restriction factor, CD59 antigen p18-20 (antigen identified by monoclonal antibodies 16.3A5, EJ16, EJ30, EL32 and G344), CD59 blood group antigen, CD59 molecule, complement regulatory protein, Ly-6-like protein, MEM43 antigen, T cell-activating protein, human leukocyte antigen MIC11, lymphocytic antigen CD59/MEM43, membrane attack complex (MAC) inhibition factor, membrane attack complex inhibition factor, membrane inhibitor of reactive lysis, protectin, surface anitgen recognized by monoclonal antibody 16.3A5
- HostRabbit
- IsotypeIgG
- Protein IDP13987
- Protein NameCD59 glycoprotein
- Scientific DescriptionThis gene encodes a cell surface glycoprotein that regulates complement-mediated cell lysis, and it is involved in lymphocyte signal transduction. This protein is a potent inhibitor of the complement membrane attack complex, whereby it binds complement C8 and/or C9 during the assembly of this complex, thereby inhibiting the incorporation of multiple copies of C9 into the complex, which is necessary for osmolytic pore formation. This protein also plays a role in signal transduction pathways in the activation of T cells. Mutations in this gene cause CD59 deficiency, a disease resulting in hemolytic anemia and thrombosis, and which causes cerebral infarction. Multiple alternatively spliced transcript variants, which encode the same protein, have been identified for this gene. [provided by RefSeq, Jul 2008]
- Storage Instruction-20°C or -80°C,2°C to 8°C
- UNSPSC12352203

![FACS analysis of HL-60 (positive) and SP2 (negative) cells using GTX18237 CD59 antibody [MEM-43] (FITC).](https://www.genetex.com/upload/website/prouct_img/normal/GTX18237/GTX18237_20191025_AP_006_136_w_23060620_103.webp)

![WB analysis of HPB-ALL cell lysate (non-reducing) using GTX29183 CD59 antibody [MEM-43/5]. Lane 1 : Original cell lysate Lane 2 : Immunoprecipitate by GTX29182](https://www.genetex.com/upload/website/prouct_img/normal/GTX29183/GTX29183_20191025_AP_001_227_w_23060722_324.webp)

![ELISA analysis of antigen using GTX60658 CD59 antibody [8D2B8]. Black : Control antigen 100ng Purple : Antigen 10ng Blue : Antigen 50ng Red : Antigen 100ng](https://www.genetex.com/upload/website/prouct_img/normal/GTX60658/GTX60658_20170912_ELISA_w_23061123_488.webp)